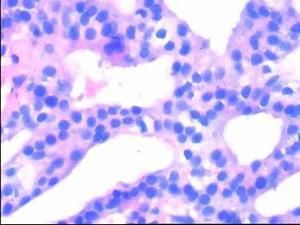

描述
血尿細胞
血尿細胞小便中的血液量超過正常量叫血尿。如果在1000毫升尿有1毫升煙,肉眼看起來小便呈血樣或洗肉水樣,這就稱為肉眼血尿。在尿液常規檢查時,如在顯微鏡下一個高倍視野中紅細胞超過5個,或12小時尿愛迪計數紅細胞超過100萬,而肉眼不能覺察者稱為顯微鏡下血尿。
發現紅色尿後,家長不要驚慌失措,首先要分清是真性血尿還是假性血尿。有些藥物可以引起紅色尿、如氨基比林、苯妥黃鈉、利福平、酚紅等;需與真性血尿區別。引起血尿的原因有許多,大致包括以下情況:
1、泌尿系統疾病如:各種腎炎(急性腎小球腎炎、病毒性腎炎、遺傳腎炎、紫癜性腎炎),結石(腎、膀胱、尿道),心及腎結核、各種先天畸形、外傷、腫瘤等。
2、全身性病症如:出血性疾病、白血病心力衰竭、敗血症、維生素C及K缺乏、高鈣尿症、新生兒出症等。
3、物理化學因素如:食物過敏、放射線照射、藥物、毒物、運動後等。為了明確病因,確定血尿發生的部位十分重要,尿三杯試驗可以了解血尿的來源,方法十分簡單。
取3隻杯子,在一次小便中,第一杯取前段尿,第二杯取中段尿,第三杯取後段尿。如第一杯為血尿表示血來自尿道;第三杯血尿為終未血尿,病變多在膀胱或後尿道;第一杯、第二杯、第三杯均呈血色即全程血尿,提示病變在腎臟或在膀胱以上的泌尿道。要明確血尿是由哪種疾病引起的,還是根據症狀和體體徵,進行各種體驗、X線及CT檢查,甚至腎臟的活組織穿刺檢查才能確診。
病因
1.腎臟及尿路疾病
(1)炎症 急慢性腎小球腎炎、急慢性腎盂腎炎、急性膀胱炎、尿道炎、泌尿系統結核、泌尿系統黴菌感染等。(2)結石 腎盂、輸尿管、膀胱、尿道,任何部位結石,當結石移動時劃破尿路上皮,既容易引起血尿亦容易繼發感染。大塊結石可引起尿路梗阻甚至引起腎功能損害。
(3)腫瘤 泌尿系統任何部位的惡性腫瘤或鄰近器官的惡性腫瘤侵及泌尿道時均可引起血尿。
(4)外傷 是指暴力傷及泌尿系統。
(5)先天畸形 多囊腎,先天性腎小球基底膜超薄,腎炎,胡桃夾現象(該病是血管先天畸形引起走行於腹主動脈和腸系膜上動脈之間的左腎靜脈受擠壓,引起頑固性鏡下血尿。右腎靜脈徑直注入下腔靜脈,而左腎靜脈須穿過腹主動脈與腸系膜上動脈所形成的夾角注入下腔靜脈。正常時此角45°~60°,若先天性此角過小或被腸系膜脂肪、腫大淋巴結、腹膜充填均可引起胡桃夾現象。診斷主要靠CT、B超、腎靜脈造影檢查。治療須手術矯正)。
2.全身性疾病
(1)出血性疾病 血小板減少性紫癜、過敏性紫癜、血友病、白血病、惡性組織細胞病、再生障礙性貧血等。(2)結締組織病 系統性紅斑狼瘡、皮肌炎、結節性多動脈炎、硬皮病等。
(3)感染性疾患 鉤端螺鏇體病、流行性出血熱、絲蟲病、感染性細菌性心內膜炎、猩紅熱等。
(4)心血管疾病 充血性心力衰竭、腎栓塞、腎靜脈血栓形成。
(5)內分泌代謝疾病 痛風腎、糖尿病腎病、甲狀旁腺功能亢進症。
(6)物理化學因素 如食物過敏、放射線照射、藥物(如磺胺、酚、汞、鉛、砷中毒,大量輸注甘露醇、甘油等)、毒物、運動後等。
3.鄰近器官疾病
子宮、陰道或直腸的腫瘤侵及尿路。血尿伴腰痛症狀者,有時發生劇烈的陣發性腰痛--腎絞痛者,可能為腎或輸尿管結石;年齡在40歲以上,無明顯症狀和疼痛的血尿,可能有泌尿系統腫瘤;血尿、腰痛與體位及日常活動有明顯關係者,如症狀在臥床休息後好轉,體力活動增加後加重,則腎下垂的可能性較大;如血尿伴全身其他部位出血者,可能由血液病引起。
尿血之症,多因熱擾血分,熱蓄腎與膀胱,損傷脈絡,致營血妄行,血從尿出而致尿血,發病部位在腎和膀胱,但與心、小腸、肝、脾有密切聯繫,並有虛實之別。常見的有心火亢盛,膀胱濕熱,肝膽濕熱,腎虛火旺,脾腎兩虧等證。
分類
1、腎臟及尿路疾病(1)炎症:急慢性腎小球腎炎、急慢性腎盂腎炎、急性膀胱炎、尿道炎、泌尿系統結核、泌尿系統黴菌感染等。
(2)結石:腎孟、輸尿管、膀胱、尿道任何部位結石,當結石移動時劃破尿,路新膜即容易引起血尿亦容易繼發感染,大塊結石可引起尿路梗阻,甚至引起腎功能損害。
(3)腫瘤:泌尿系統任何部位的惡性腫瘤或鄰近器官的惡性腫瘤侵及泌尿道時,均可引起一血尿發生。
(4)外傷:是指暴力傷及泌尿系統。
(5)藥物刺激:如磺胺酚汞鉛砷中毒大量輸注甘露醇甘油等。
(6)先天畸形:多囊腎、先天性腎小球基底膜超薄腎炎。胡桃夾現象,該病是血管先天畸形引起。走行於腹主動脈和腸系膜上動脈之間的左腎靜脈受擠壓,引起頑固性鏡下血尿稱胡桃夾現象。右腎靜脈徑直注入下腔靜脈,而左腎靜脈須穿經腹主動脈與腸系膜上動脈所形成的夾角注人下腔靜脈。正常時此角45°-60°,若先天性此角過小或被腸系膜、脂肪、腫大淋巴結、腹膜充填均可引起胡桃夾現象。診斷主要靠CT、B超、腎靜脈造影檢查,治療須手術矯正。
2、全身性疾病
(1)出血性疾病:血小板減少性紫癲,過敏性紫癲,血友病,白血病,惡性組織細胞病,再生障礙性貧血等。
(2)結締組織病:系統性紅斑狼,瘡皮肌炎。結節性多動脈炎,硬皮病等。
(3)感染性疾患:鉤端螺鏇體病,流行性出血熱,絲蟲病,感染性細菌性心內膜炎,猩紅熱等。
(4)心血管病病:充血性心力衰竭,腎栓塞,腎靜脈血栓形成。
(5)內分泌代謝疾病:痛風腎,糖尿病腎病,甲狀旁腺功能亢進症。
機理
血尿總是嚴重的症狀,無論是肉眼血尿還是鏡下血尿均為病態,鏡下血尿的判定標準目前各家尚不統一。多數學者認為,取10ml新鮮尿,液離心沉澱(1800min/L5min)每高倍視野超過3個紅細胞或非離心尿連續看10個視野平均每高倍視野1個紅細胞,或每1小時尿中紅細胞計數超過50萬,均展示尿中紅細胞異常增加,稱為鏡下血尿。一個健康人尿中不輕易出現紅細胞,作為臨床醫師這種概念應當牢記。當尿中含1ML血液時即可見到肉眼血尿;通常用三杯試驗區分出血部位,將患者同一時間排出的尿液分、前、中、後三杯,若血尿僅在第一杯出現,說明血來自尿道;若血僅在最後出現表示血來自膀胱稱終末血尿;假如三杯均勻血尿,稱全程血尿表示血來自腎臟,來自腎臟的血尿一般不出現血凝塊,不同於來自膀胱的肉眼血尿,尿的三杯試驗對出血部位的判斷有參考價值,但是若出血量很大或出血量較少時,有時判斷不可靠,應引起臨床醫師注意,肉眼血尿見於結石、腫瘤、出血熱、多囊腎、血友病,腎外傷等。併發症狀
1、伴腎絞痛者起源於結石、乾酪性物質、血凝塊等的尿路梗阻。
2、伴膀胱刺激症狀(尿頻、尿急、尿痛)者,提示病變位於膀胱或後尿道。
3、伴高血壓者可見於急、慢性腎小球腎炎,急進型高血壓病,先天性多囊腎,腎動脈栓塞,結節性多動脈炎等。
4、伴腰部包塊者可見於腎腫瘤、先天性多囊腎。
5、伴皮膚黏膜出血者,可見於敗血症、感染性心內膜炎、流行性出血熱、鉤端螺鏇體病、血液病等。
問診要點:
①尿的顏色,如為紅色應進一步了解是否進食引起紅色尿的藥物或食物如;是否為女性的月經期,以排除假性血尿;
②血尿出現在尿程的哪一段出;是否全程血尿,有無血塊;
③是否伴有全身或泌尿系統症狀;
④有無腰腹部新近外傷和泌尿道器械檢查史;
⑤過去是否有高血壓和腎炎史;
⑥家中有無耳聾和腎炎史。
病理診斷
 血尿--實驗室檢查
血尿--實驗室檢查2、體格檢查:除注意全身查體外,泌尿系統應是查體重點,腎區壓痛,叩擊痛上輸尿管壓痛點,腎臟雙合診等。
3、實驗室檢查尿常規檢查是最常用也是最重要的檢查:除此之外應注意腎功能的檢查,根據可能的病因有選擇的檢查自身抗體。血漿蛋白電泳,凝血溶血機制的檢查,骨髓的檢查等對血液疾病引起的。血尿的診斷是必要的,伴有全身出血傾向的血尿應查DIC,出血熱抗體,位相顯微鏡尿液的檢查是一項簡單無創傷的檢查,通過腎小球濾過的紅細胞常常變形才能濾出,可表現桑格形、梭形、摺疊形、多邊形、三角形、變形的紅細胞一般占80%以上;未通過腎小球的紅細胞往往以原形排出,有時因細胞內脫水僅表現皺縮的紅細胞,不同於變形的紅細胞。
(1)尿沉渣中管型,特別是紅細胞管型,表示出血來自腎實質,高度提示為腎小球腎炎。
(2)尿蛋白測定,血尿伴有較嚴重的蛋白尿幾乎都是腎小球性血尿的象徵。新鮮尿標本即使發生溶血,尿蛋白量也不會很大,因而肉眼血尿的收拾量>1g/24h或鏡下血尿的蛋白量>500mg/24h提示腎小球血尿。
(3)尿中含有免疫球蛋白的顆粒管型(IGM)。
(4)尿紅細胞形態,用位相顯微鏡檢查尿沉渣,是目前鑑別腎小球性或非腎小球性血尿的最常用的方法。當尿紅細胞數>8×106/L,其中異形紅細胞(環形、靶形、芽胞形等)>30%,應視為腎小球性血尿。尿中尿蛋白定量>500mg/24小時,常提示為腎小球性血尿。如腎孟、輸尿管、膀胱或尿道出血(即非腎小球性出血)其紅細胞的形成,大小絕大多數是正常的,僅小部分為畸形紅細胞。
4、器械檢查:
(1)B超:對診斷腎臟的大小、輪廓腎積水、上輸尿管擴張、結石、腫瘤、胡桃夾現象、多囊腎有幫助,胡桃夾現象時腹主動脈左方的左腎靜脈直徑比腹主動脈前方的左腎靜脈寬1倍以上。
(2)CT和MRI檢查:主要用於腫瘤,結石,結核的診斷。
(3)膀胱鏡的檢查:對診斷膀胱結核、腫瘤、結石、潰瘍有助。因腎功能受損,不能行靜脈腎孟造影時,可在膀胱鏡檢查的同時行逆行造影,以便確定梗阻的部位和原因。
(4)腎活檢檢查:對腎實質性疾患確定病因和性質十分必要。
(5)ECT檢查:對腎小球的濾過率,濾過功能和腎血流量腎梗死的診斷有幫助。
臨床表現
1.尿顏色的改變
血尿的主要表現是尿顏色的改變,除鏡下血尿顏色正常外,肉眼血尿根據出血量多少而呈不同顏色。尿呈淡紅色像洗肉水樣,提示每升尿含血量超過1mL。出血嚴重時尿可呈血液狀。腎臟出血時,尿與血混合均勻,尿呈暗紅色;膀胱或前列腺出血尿色鮮紅,有時有血凝塊。
2.分段尿異常
將全程尿分段觀察顏色,如尿三杯試驗,用三個清潔玻璃杯分別留起始段,中段和終末段尿觀察,如起始段血尿提示病變在尿道;終末段血尿提示出血部位在膀胱頸部,三角區或後尿道的前列腺和精囊腺;三段尿均呈紅色即全程血尿,提示血尿來自腎臟或輸尿管。
3.腎性或腎後性血尿
鏡下血尿顏色正常,但顯微鏡檢查可確定血尿,並可判斷是腎性或腎後性血尿。鏡下紅細胞大小不一形態多樣為腎小球性血尿,見於腎小球腎炎。
4.症狀性血尿
血尿的同時患者伴有全身或局部症狀。而以泌尿系統症狀為主。如伴有腎區鈍痛或絞痛提示病變在腎臟。膀胱和尿道病變則常有尿頻尿急和排尿困難。
5.無症狀性血尿
部分患者血尿既無泌尿道症狀也無全身症狀,見於某些疾病的早期,如腎結核,腎癌或膀胱癌早期。
6.伴隨症狀
①血尿伴腎絞痛是腎或輸尿管結石的特徵;②血尿伴尿流中斷見於膀胱和尿道結石;③血尿伴尿流細和排尿困難見於前列腺炎、前列腺癌;④血尿伴尿頻尿急尿痛見於膀胱炎和尿道炎,同時伴有腰痛,高熱畏寒常為腎盂腎炎;⑤血尿伴有水腫,高血壓,蛋白尿見於腎小球腎炎;⑥血尿伴腎腫塊,單側可見於腫瘤,腎積水和腎囊腫;雙側腫大見於先天性多囊腎,觸及移動性腎臟見於腎下垂或遊走腎;⑦血尿伴有皮膚黏膜及其他部位出血,見於血液病和某些感染性疾病;⑧血尿合併乳糜尿見於絲蟲病,慢性腎盂腎炎。
鑑別診斷
 血尿
血尿2、尿路感染腎盂炎,腎盂腎炎稱上尿路感染;膀胱炎,尿道炎稱下尿路感染,不能準確定位時籠統稱尿路感染,或稱泌尿系統感染感染所引起的血尿,一般為鏡下血尿只有膀胱三角區炎症約l/3病例出現肉眼血尿,尿路感染的臨床表現是感染中毒症狀局部症狀,是膀胱刺激症狀,尿常規檢查有大量膿細胞,或大量白細胞膿細胞管型和白細胞管型有一定特異性,尿培養可找到致病菌,抗生素治療有效,一般不易與腎炎相混淆。
3、腎結核晚期都是累及整個泌尿系統,一般都存在鏡下或肉眼血尿,典型病例洗肉水樣尿,病程長,膀胱刺激症狀較一般細菌感染更明顯,腎外往往找到結核病灶,一般抗生素治療無效,B超、CT、IVP腎盂造影檢查幫助較大,典型的影像學表現為一側腎結核對側腎積水,尿中可找到抗酸桿菌可確診。值得注意的是久治不愈的膿尿應想到腎結核的可能,應進一步行細菌學檢查,加以證實。尿集菌,法找抗酸桿菌其陽性率70%,故臨床疑腎結核時應反覆檢查,必要時做結核菌培養,但需時較長一般1-3個月。遠不如尿液塗片找抗酸桿菌重要。
4、結石泌尿系統容易患結石症,當結石活動時,劃破黏膜,出現鏡下或肉眼血尿。同時伴有絞痛是其特點,絞痛從腎區開始沿側腹向膀胱大腿內側放射,影像學檢查可發現結石部位、大小、形狀、梗阻部位。結石容易同時合併感染,是複雜性腎盂腎炎常見原因之一,須清除結石,抗感染治療時才能奏效。
5、腫瘤
腫瘤是常見引起肉眼或鏡下血尿原因,腎癌無痛性全程血尿是其特點,男性發病率高,CT檢查時CT值高是與腎黃色肉芽腫的主要鑑別點(黃色肉芽腫是腎內一種良性腫瘤病程長CT檢查時CT值低需手術治療)膀胱癌易誤診為膀胱炎,但病程經久不愈,老年人久治不愈的膀胱激症狀,應想到膀胱癌的可能,B超、CT膀胱鏡檢查可及早確診及時採取相應的治療手段。6、結締組織病是一組自身免疫性疾患,最常見的是系統性紅斑狼瘡,一般都是鏡下血尿,除腎臟損害外。心臟、肝臟、腦神經損害也常見,面部蝶形紅斑,手、足暴露部位,有皮疹,關節炎,脫髮,口腔潰瘍等。實驗室檢查,對確診十分重要如血中找到狼瘡細胞抗核抗體陽性抗雙鏈DNA檢查,有一定特異性,血中自身免疫抗體檢查如:抗SM抗U1RNP抗SS-A叭抗SS-B醜抗Sc1-70抗Jo-1抗RID等檢查可表現陽性。
7.其他血尿是一個臨床十分常見的症狀,原因非常複雜,血液系統疾病,幾乎都可引起血尿。很多傳染病如流行性出血熱、鉤端螺鏇體病、麻疹、腮腺炎等。均可引起血尿。藥物或重金屬鹽類中毒亦可見到,一般都有特殊病史及特殊的臨床表現,一般診斷不困難,伴有腰部上腹部腫塊的血尿,見於腫瘤結核多囊腎等。
治療方式
 血尿--治療
血尿--治療2、終末血尿:排尿行將結束時出現血尿,病變多在膀胱三角區、膀胱頸部或後尿道。
3、全程血尿:血尿出現在排尿的全過程,出血部位多在膀胱、輸尿管或腎臟。
以上三種血尿,可用尿三杯試驗加以區別。
(1)臥床休息,儘量減少劇烈的活動,必要時可服用苯巴比妥,安定等鎮靜安眠藥。
(2)大量飲水,減少尿中鹽類結晶,加快藥物和結石排泄,腎炎已發生浮腫者應少飲水。
(3)套用止血藥物,如安絡血,止血敏,維生素K,還可合用維生素C。
(4)慎用導致血尿的藥物,尤其是已經有腎臟病的人。
(5)血尿是由泌尿系感染引起,可口服和注射抗生素和尿路清潔劑,如氟哌酸、呋喃嘧啶、氨苄青黴素、青黴素、滅滴靈等藥。
(6)泌尿繫結石常有劇烈腹痛,可口服顛茄片654—2、阿托品以解痙止痛。
(7)血尿病因複雜,有的病情很嚴重。應儘早去醫院檢查確診,進行徹底治療,腎結核和腎腫瘤在明。
患者檢出血尿後心裡非常緊張,迫切想知道血尿來自身體哪個部位。一般地說95%以上的血尿是泌尿系本身疾病所致:
青少年的血尿以泌尿系統感染性疾病,腎小球疾病,先天性泌尿系統異常和高鈣尿症多見。
中年患者則以尿路感染,結石和膀胱腫瘤常見。
40歲至60歲的患者男性以膀胱腫瘤,腎和輸尿管腫瘤多見,女性則以尿路感染,結石常見。
超過60歲的男性患者以前列腺肥大,前列腺癌,尿路感染多見,女性則以尿路感染,腎或膀胱腫瘤多見。
血尿患者需要注意
1、血尿病人,特別有肉眼血尿的病人,應該絕對臥床休息。如系泌尿系統結石引起的血尿伴腎絞痛者,可在原地做蹦跳動作,通過上下震動,可促使結石排出,疼痛和血尿也隨之減輕。
2、血尿病人必須大量飲水或吃西瓜等,以增加尿量,防止形成血塊,阻塞尿道。
3、如果確定是腎臟、膀胱、尿道出血,在腰部、下腹部、會陰部放置冰袋或敷冷水毛巾,有利於止血,減輕、減緩出血。
4、血尿病人忌吃一切辛辣刺激性食品,如白糖、韭菜、芥末、辣椒等。少吃烤膾肥膩食品、海腥發物和溫熱性食物。注意吃一些有涼血、止血作用的食品,如馬蘭頭、薺菜、鮮藕、荸薺、冬瓜、西瓜、蠶豆、柿餅、蓮子、綠豆、赤豆等。蘋果、梨、橘子等含維生素C和P較多的果品亦可多吃。
預防方法
發現血尿時首先應確定是否為真性血尿,即排除某些原因引起的假性血尿,和紅顏色尿前者如由於月經,痔出血或尿道口附近疾患產生出血混到尿液中所致;後者如接觸某些顏料或內服利福平等藥物以及某些毒物(酚一氧化碳氯仿蛇毒)藥物(磺胺奎寧),擠壓、傷燒、瘧疾、錯型輸血等原因所致的血紅蛋白尿,或肌紅蛋白尿而一過性血尿可由花粉,化學物質或藥物過敏引起,月經期、劇烈運動後、病毒感染亦可發生,一般無重要意義,當排除上述各種情況,並作多次檢查均為血尿時才應重視通過病史,體檢、化驗室檢查和其他輔助檢查作出診斷,確定了為真性血尿後,應進行血尿的定位診斷,區分血尿來自腎實質還是來自尿路:①如在尿沉渣中發現管型,特別是紅細胞管型,表示出血來自腎實質;②血尿伴有較嚴重的蛋白尿,幾乎都是腎小球性血尿的徵象;③如尿中能發現含有免疫球蛋白的管型,則多為腎實質性出血;④腎小球疾患,導致的血尿其紅細胞絕大部分是畸形的。其形態各異,大小明顯差異,而非腎小球性血尿,其紅細胞絕大多數大小正常,僅少部分為畸形紅細胞。非腎小球性血尿的病因十分複雜,應特別警惕泌尿生殖系統的惡性腫瘤,兩類血尿對症治療原則也是相反的,腎小球性血尿常須抗凝、抗栓、抗血小板聚集或活血化瘀治療,而非腎小球性血尿常須套用止血療法。護理保健
 血尿
血尿2、平時養成多飲水習慣(磁化水)。
3、少抽菸或不抽菸,少吃刺激性食物,忌服:腥辣、水產品,(蝦、蟹)辣椒,蒜、生蔥,香菜,肉,馬肉,驢肉。
4、積極治療泌尿系統的炎症、結石等疾病。
5、做好染料、橡膠、塑膠等工具生產中的防護保健工作。6、在平時生活工作中,不能經常使膀胱高度充盈,感覺的尿意即要去排尿,以減少尿液在膀胱存留時間過長。
7、注意勞逸結合,避免劇烈運動。
中醫護理
要細緻觀察血尿色、量的變化,以及血壓、體溫、面色、舌象、脈搏、神志的變化,以利於把握血尿的轉歸。
在臨床上,正確掌握中醫望、聞、問、切,對於護理血尿患者,有十分重要的意義。
若見患者目眩,下焦熱盛或中氣虛弱,或脾腎陽虛護理中應注意調理患者的飲食,忌食辛辣、刺激性食物,做好口腔護理,保持清潔。
要細緻觀察血尿色、量的變化,以及血壓、體溫、面色、舌象、脈搏、神志的變化,以利於把握血尿的轉歸,若患者血尿同時,伴尿痛,排尿困難,恥骨上,會陰部鈍痛或劇痛。
腎區鈍痛或絞痛明顯者,則可能有再次尿血或尿血加重的趨勢,注意有結石的可能。又如尿血鮮紅,舌紅脈數,多為下焦熱盛;久病尿血,舌淡,脈細弱,多因脾不統血。
總之:發現血尿及早檢查、確診及時治療,一時難以確診的要到醫院定期複查。
營養食譜
 阿膠糯米粥
阿膠糯米粥營養食譜
阿膠糯米粥
2製作先將阿膠搗碎,待將糯米煮成粥後,再放入阿膠稍煮,攪拌令其烊化後即可食用。
3功效此方具有養血止血、滋陰潤肺之功效,適用於便血、尿血、吐血、咯血等多種出血症。
4炒藕片或涼拌鮮藕片:鮮藕片200克。清炒時可放少許低鈉鹽調味,涼拌時可先將藕片用開水煮一會兒後濾水,加少量鹽或糖涼拌。功效清熱涼血止血,用於腎炎血尿屬於血熱或濕熱者,亦用於過敏性紫癜性腎炎。
5木耳紅棗花生湯:黑木耳30克、紅棗50克、紅皮花生30克。共放入鍋中小火燉爛,食前可加少許白糖調味。功能健脾補血止血,用於腎炎血尿屬於脾氣虛弱不能攝血者。
營養產品調理建議:
(1)3倍用量:維生素C,大蒜精油
(2)2倍用量:蜂膠,B族維生素。
(3)1倍用量:β-胡蘿蔔素,蛋白質粉(胺基酸片)蛋白質粉(倍健胺基酸片):為免疫系統製造抵抗細菌的抗體提供原料,增強體質。
維生素C:抗氧化、解毒、增加免疫力、防止復發,促進傷口的癒合。
大蒜精油:天然的廣譜抗生素,抑制各種感染。
蜂膠:抗菌消炎,增加免疫力。
β-胡蘿蔔素:保護受損的黏膜,強化免疫系統,增強抵抗力。
B族維生素:減輕使用抗生素後的毒副作用。
區別聯繫
 血尿
血尿血尿的主語中心語是尿,血放在尿的前面起修飾作用,意指尿的顏色呈血色。這裡的核心是含有血紅細胞的尿,不是血。
尿血的主語中心語是血,尿放在血的前面起形容作用,意指小便時帶有血。這裡的核心是隨尿一起排出的血,不是尿。還可以把尿血中的“尿”看成動詞,如尿尿中的前一個“尿”便是動詞,尿血即可以理解為通過尿道把一部分血紅細胞排出來。
血尿包括鏡下血尿和肉眼血尿,前者是指尿色正常,須經顯微鏡檢查方能確定,通常離心沉澱後的尿液鏡檢每高倍鏡視野下有紅細胞3個以上。後者指尿呈洗肉水色或血色,肉眼即可見是血尿。
尿血指小便中混有血液或挾雜血塊。血尿或是尿血都表明身體存在問題,建議及早到醫院檢查確診,及早治療。
血尿和尿血雖是不同的概念,但它們是緊密聯繫在一起的!

